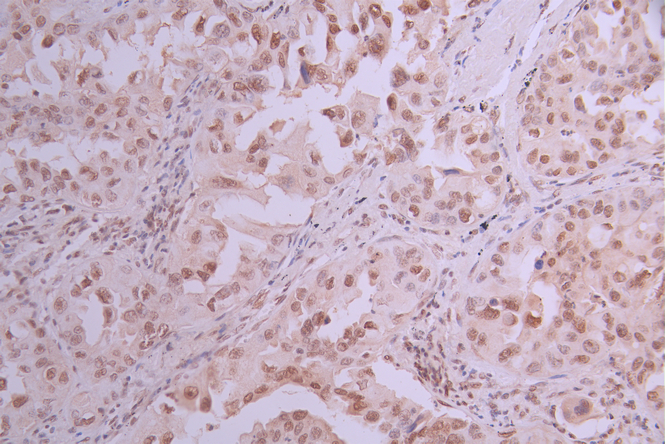

METTL3 Recombinant Monoclonal Antibody
-
中文名稱:METTL3 Recombinant Monoclonal Antibody
-
貨號(hào):CSB-RA559330A0HU
-
規(guī)格:¥1320
-
圖片:
-
Western Blot
Positive WB detected in: Jurkat whole cell lysate(30μg),HT-29 whole cell lysate(30μg),Hela whole cell lysate(30μg),K562 whole cell lysate(30μg),NIH/3T3 whole cell lysate(30μg)
All lanes: METTL3 antibody at 1:1000
Secondary
Goat polyclonal to rabbit IgG at 1/40000 dilution
Predicted band size: 64 kDa
Observed band size: 70 kDa
Exposure time:2min -
IHC image of CSB-RA559330A0HU diluted at 1:100 and staining in paraffin-embedded human lung cancer performed on a Leica BondTM system. After dewaxing and hydration, antigen retrieval was mediated by high pressure in a citrate buffer (pH 6.0). Section was blocked with 10% normal goat serum 30min at RT. Then primary antibody (1% BSA) was incubated at 4°C overnight. The primary is detected by a Goat anti-rabbit polymer IgG labeled by HRP and visualized using 0.05% DAB.
-
-
其他:
產(chǎn)品詳情
-
Uniprot No.:
-
基因名:
-
別名:adoMet-binding subunit of the human mRNA (N6-adenosine)-methyltransferase antibody; IME4 antibody; M6A antibody; Methyltransferase like protein 3 antibody; Methyltransferase-like protein 3 antibody; METTL3 antibody; mRNA (2'-O-methyladenosine-N(6)-)-methyltransferase antibody; mRNA m(6)A methyltransferase antibody; MT-A70 antibody; MTA70 antibody; MTA70_HUMAN antibody; N6 adenosine methyltransferase 70 kDa subunit antibody; N6-adenosine-methyltransferase 70 kDa subunit antibody
-
反應(yīng)種屬:Human, Mouse
-
免疫原:A synthesized peptide derived from human METTL3
-
免疫原種屬:Homo sapiens (Human)
-
標(biāo)記方式:Non-conjugated
-
克隆類型:Monoclonal
-
抗體亞型:Rabbit IgG
-
純化方式:Affinity-chromatography
-
克隆號(hào):6D10
-
濃度:It differs from different batches. Please contact us to confirm it.
-
保存緩沖液:Rabbit IgG in 10mM phosphate buffered saline , pH 7.4, 150mM sodium chloride, 0.05% BSA, 0.02% sodium azide and 50% glycerol.
-
產(chǎn)品提供形式:Liquid
-
應(yīng)用范圍:ELISA, WB, IHC
-
推薦稀釋比:
Application Recommended Dilution WB 1:500-1:2000 IHC 1:50-1:200 -
Protocols:
-
儲(chǔ)存條件:Upon receipt, store at -20°C or -80°C. Avoid repeated freeze.
-
貨期:Basically, we can dispatch the products out in 1-3 working days after receiving your orders. Delivery time maybe differs from different purchasing way or location, please kindly consult your local distributors for specific delivery time.
-
用途:For Research Use Only. Not for use in diagnostic or therapeutic procedures.
相關(guān)產(chǎn)品
靶點(diǎn)詳情
-
功能:The METTL3-METTL14 heterodimer forms a N6-methyltransferase complex that methylates adenosine residues at the N(6) position of some RNAs and regulates various processes such as the circadian clock, differentiation of embryonic and hematopoietic stem cells, cortical neurogenesis, response to DNA damage, differentiation of T-cells and primary miRNA processing. In the heterodimer formed with METTL14, METTL3 constitutes the catalytic core. N6-methyladenosine (m6A), which takes place at the 5'-[AG]GAC-3' consensus sites of some mRNAs, plays a role in mRNA stability, processing, translation efficiency and editing. M6A acts as a key regulator of mRNA stability: methylation is completed upon the release of mRNA into the nucleoplasm and promotes mRNA destabilization and degradation. In embryonic stem cells (ESCs), m6A methylation of mRNAs encoding key naive pluripotency-promoting transcripts results in transcript destabilization, promoting differentiation of ESCs. M6A regulates the length of the circadian clock: acts as an early pace-setter in the circadian loop by putting mRNA production on a fast-track for facilitating nuclear processing, thereby providing an early point of control in setting the dynamics of the feedback loop. M6A also regulates circadian regulation of hepatic lipid metabolism. M6A regulates spermatogonial differentiation and meiosis and is essential for male fertility and spermatogenesis. Also required for oogenesis. Involved in the response to DNA damage: in response to ultraviolet irradiation, METTL3 rapidly catalyzes the formation of m6A on poly(A) transcripts at DNA damage sites, leading to the recruitment of POLK to DNA damage sites. M6A is also required for T-cell homeostasis and differentiation: m6A methylation of transcripts of SOCS family members (SOCS1, SOCS3 and CISH) in naive T-cells promotes mRNA destabilization and degradation, promoting T-cell differentiation. Inhibits the type I interferon response by mediating m6A methylation of IFNB. M6A also takes place in other RNA molecules, such as primary miRNA (pri-miRNAs). Mediates m6A methylation of Xist RNA, thereby participating in random X inactivation: m6A methylation of Xist leads to target YTHDC1 reader on Xist and promote transcription repression activity of Xist. M6A also regulates cortical neurogenesis: m6A methylation of transcripts related to transcription factors, neural stem cells, the cell cycle and neuronal differentiation during brain development promotes their destabilization and decay, promoting differentiation of radial glial cells. METTL3 mediates methylation of pri-miRNAs, marking them for recognition and processing by DGCR8. Acts as a positive regulator of mRNA translation independently of the methyltransferase activity: promotes translation by interacting with the translation initiation machinery in the cytoplasm. Its overexpression in a number of cancer cells suggests that it may participate in cancer cell proliferation by promoting mRNA translation. During human coronorivus SARS-CoV-2 infection, adds m6A modifications in SARS-CoV-2 RNA leading to decreased DDX58/RIG-I binding and subsequently dampening the sensing and activation of innate immune responses.
-
基因功能參考文獻(xiàn):
- Findings suggest that METTL3 plays very important oncogenic roles in ovarian carcinoma development and/or aggressiveness by stimulating AXL translation and EMT. PMID: 30249526
- Data show that hepatitis B X-interacting protein (HBXIP) modulated Methyltransferase-like 3 (METTL3) by inhibiting miRNA let-7g, which down-regulated the expression of METTL3 by targeting its 3'UTR. PMID: 29174803
- Study reports the importance of m6A modification in glioma stem-like cells and uncovers METTL3 as a potential molecular target in glioblastoma therapy. PMID: 28991227
- The role of METTL3 in pancreatic cancer cells drug resistance and radiation resistance.METTL3 was associated with mitogen-activated protein kinase cascades, ubiquitin-dependent process and RNA splicing and regulation of cellular process. PMID: 29345285
- METTL3 is soluble and inactive while the catalytic center of METTL14 is degenerated and thus also inactive. In addition, the C-terminal RGG repeats of METTL14 are required for METTL3/14 activity by contributing to RNA substrate binding. PMID: 29348140
- data define METTL3 as a regulator of a chromatin-based pathway that is necessary for maintenance of the leukaemic state and identify this enzyme as a potential therapeutic target for acute myeloid leukaemia PMID: 29186125
- loss of METTL3 leads to increased levels of phosphorylated AKT, which contributes to the differentiation-promoting effects of METTL3 depletion. Overall, these results provide a rationale for the therapeutic targeting of METTL3 in myeloid leukemia PMID: 28920958
- The structure reveals the heterodimeric architecture of the complex and donor substrate binding by METTL3. Structure-guided mutagenesis indicates that METTL3 is the catalytic subunit of the complex, whereas METTL14 has a degenerate active site and plays non-catalytic roles in maintaining complex integrity and substrate RNA binding. PMID: 27627798
- For the methylation of adenosine in RNA, Mettl3 is the catalytically active subunit, while Mettl14 plays a structural role critical for substrate recognition. PMID: 27373337
- METTL3 enhances mRNA translation through an interaction with the translation initiation machinery in lung adenocarcinoma cells. PMID: 27117702
- miR-33a can attenuatenon-small-cell lung carcinoma cells proliferation via targeting to the 3'-untranslated region of METTL3 mRNA. PMID: 27856248
- Structure of the METTL3-METTL14 complex PMID: 27281194
- genetic inactivation impaired embryonic stem cells differentiation PMID: 25456834
- Study identifies m(6)A methylation sites on many clock gene transcripts and shows that specific inhibition of m(6)A methylation by silencing of the m(6)A methylase Mettl3 is sufficient to elicit circadian period elongation and RNA processing delay. PMID: 24209618
顯示更多
收起更多
-
亞細(xì)胞定位:Nucleus. Nucleus speckle. Cytoplasm.
-
蛋白家族:MT-A70-like family
-
組織特異性:Widely expressed at low level. Expressed in spleen, thymus, prostate, testis, ovary, small intestine, colon and peripheral blood leukocytes.
-
數(shù)據(jù)庫鏈接:
Most popular with customers
-
-
YWHAB Recombinant Monoclonal Antibody
Applications: ELISA, WB, IHC, IF, FC
Species Reactivity: Human, Mouse, Rat
-
Phospho-YAP1 (S127) Recombinant Monoclonal Antibody
Applications: ELISA, WB, IHC
Species Reactivity: Human
-
-
-
-
-